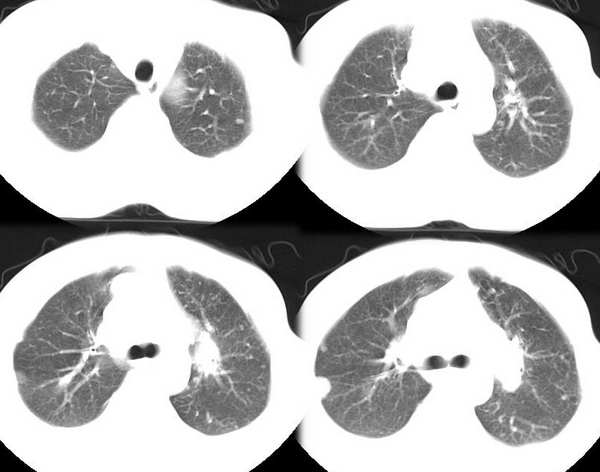

医影在线
标题: CT2665:胸部病变,应项雪祝各位战友新春快乐!新年送大礼 [打印本页]
作者: 应项雪 时间: 2006-1-31 18:45
标题: CT2665:胸部病变,应项雪祝各位战友新春快乐!新年送大礼
男35y,皮鞋工10余年,近月来发烧,咳血,胸痛,半年前胸片正常,左锁骨上淋巴结肿大,按炎性治疗无效。行ct检查。发平扫片暂无增强片

[本贴已被 jiajie 于 2006-1-31 12:42:06 修改过]
作者: 东北 时间: 2006-1-31 18:53
肺癌 肺内转移
作者: wawaquan 时间: 2006-1-31 19:10
双肺散在分布多发大小不等圆形、类圆形结节影,多数边界清晰,部分有融合,以肺周边部(胸膜下、隔上及纵隔旁)为著;纵隔肺门淋巴结增大;双侧少量胸水。
男35y,皮鞋工10余年,近月来发烧,咳血,胸痛,半年前胸片正常,左锁骨上淋巴结肿大,按炎性治疗无效。
考虑:肺转移瘤可能大。建议穿刺活检。
作者: cefcmj 时间: 2006-1-31 19:38
临床: 男35y,皮鞋工10余年,近月来发烧,咳血,胸痛,半年前胸片正常,左锁骨上淋巴结肿大,按炎性治疗无效。
影像:两肺散在分布多发大小不等圆形、类圆形结节影,多数边界清晰,部分有融合,纵隔肺门淋巴结增大;双侧少量胸水。
诊断:肺癌肺转移瘤可能大;不除外肺转移瘤。
作者: sxdongfang 时间: 2006-1-31 20:01
各位站友新年好!愿站友们新年事业身体健康、万事如意、合家欢乐、安全永驻!
病历资料同前。
左肺癌(周围型)伴纵隔淋巴结、两肺、胸膜、左锁骨上(临床支持)广泛转移。
作者: 龙在野 时间: 2006-1-31 20:41
肺转移瘤
作者: 应项雪 时间: 2006-1-31 20:45
应项雪再谢jiajie及各位影像人!愿站友们新年事业身体健康、万事如意、合家欢乐、安全永驻!
作者: xiaoniu 时间: 2006-1-31 21:02
标题: [讨论]
双肺分布大小不等圆形、类圆形结节肿块阴影,边界尚清晰,部分融合,肺纵窗比率>50%,再根据临床资料综合分析,霉菌感染可能性大。
[本贴已被 xiaoniu 于 2006-1-31 13:10:22 修改过]
作者: lnhsdm 时间: 2006-1-31 21:34
左肺癌,肺内转移,纵隔淋巴结转移,胸腔积液
作者: liuzhiguang 时间: 2006-1-31 23:00
左肺癌,肺内转移,纵隔淋巴结转移,胸腔积液
作者: baixiongjun 时间: 2006-1-31 23:10
支持周围型肺癌,建议追踪
作者: 同 时间: 2006-1-31 23:20
左侧肺癌,两肺多发大小不等结节影及纵隔淋巴结肿大,考虑转移,双侧胸腔积液。
作者: ZJC 时间: 2006-1-31 23:39
两肺多发性结节影,左肺门淋巴结肿大,病人发烧,体表淋巴结肿大。考虑肺内及左肺门淋巴瘤。
作者: jiangjing 时间: 2006-2-1 00:17
临床: 男35y,皮鞋工10余年,近月来发烧,咳血,胸痛,半年前胸片正常,左锁骨上淋巴结肿大,按炎性治疗无效。
影像:两肺散在分布多发大小不等圆形、类圆形结节影,以近胸膜面为明显,多数边界清晰,部分有融合,纵隔肺门淋巴结增大;双侧少量胸水。
考虑:1临床: 男35y,皮鞋工10余年,近月来发烧,咳血,胸痛,半年前胸片正常,左锁骨上淋巴结肿大,按炎性治疗无效。
影像:两肺散在分布多发大小不等圆形、类圆形结节影,多数边界清晰,部分有融合,纵隔肺门淋巴结增大;双侧少量胸水。
诊断:1肺转移瘤。2肺癌肺转移瘤 3淋巴瘤。4其他待排
作者: 国王 时间: 2006-2-1 02:25
肺内转移,纵隔淋巴结转移,胸腔积液
作者: kbzyycm 时间: 2006-2-1 02:53
左肺癌,肺内转移,纵隔淋巴结转移,胸腔积液
作者: weixuan 时间: 2006-2-1 03:02
肺转移瘤可能大
作者: yang4132 时间: 2006-2-1 03:30
左肺癌两肺,纵隔胸膜转移可能性大。
作者: ysxyy 时间: 2006-2-1 03:36
支持18楼。
作者: 阿圣 时间: 2006-2-1 04:52
左肺癌,肺内转移,纵隔淋巴结转移,胸腔积液
作者: bty0902 时间: 2006-2-1 06:10
左肺癌,肺内及纵隔淋巴结转移,胸腔积液
作者: ssl1_1 时间: 2006-2-1 06:15
左肺癌,肺内及纵隔淋巴结转移,胸腔积液
作者: 流星1234 时间: 2006-2-1 06:29
左肺癌,肺转移,纵隔淋巴转移,胸腔积液.
作者: qinwei260 时间: 2006-2-1 17:09
双肺散在分布多发圆形、类圆形结节影,边界清晰,部分有融合,以肺周边部胸膜下、隔上及纵隔旁为著;纵隔肺门淋巴结增大,双侧少量胸水,左锁骨上淋巴结肿大,按炎性治疗无效,首先考虑淋巴瘤,肺转移瘤不排除,
作者: 谢起伟 时间: 2006-2-1 17:49
肺癌肺转移
作者: huangaiying1 时间: 2006-2-10 02:38
左肺癌,肺内纵隔转移,胸腔积液
作者: jbhaaa111 时间: 2006-2-12 03:49
肺癌 肺内肺门纵隔转移
作者: shibing 时间: 2015-6-1 10:55
左肺癌,肺内转移,纵隔淋巴结转移,胸腔积液
| 欢迎光临 医影在线 (http://bbs.radida.com/bbs/) |
Powered by Discuz! X3.2 |